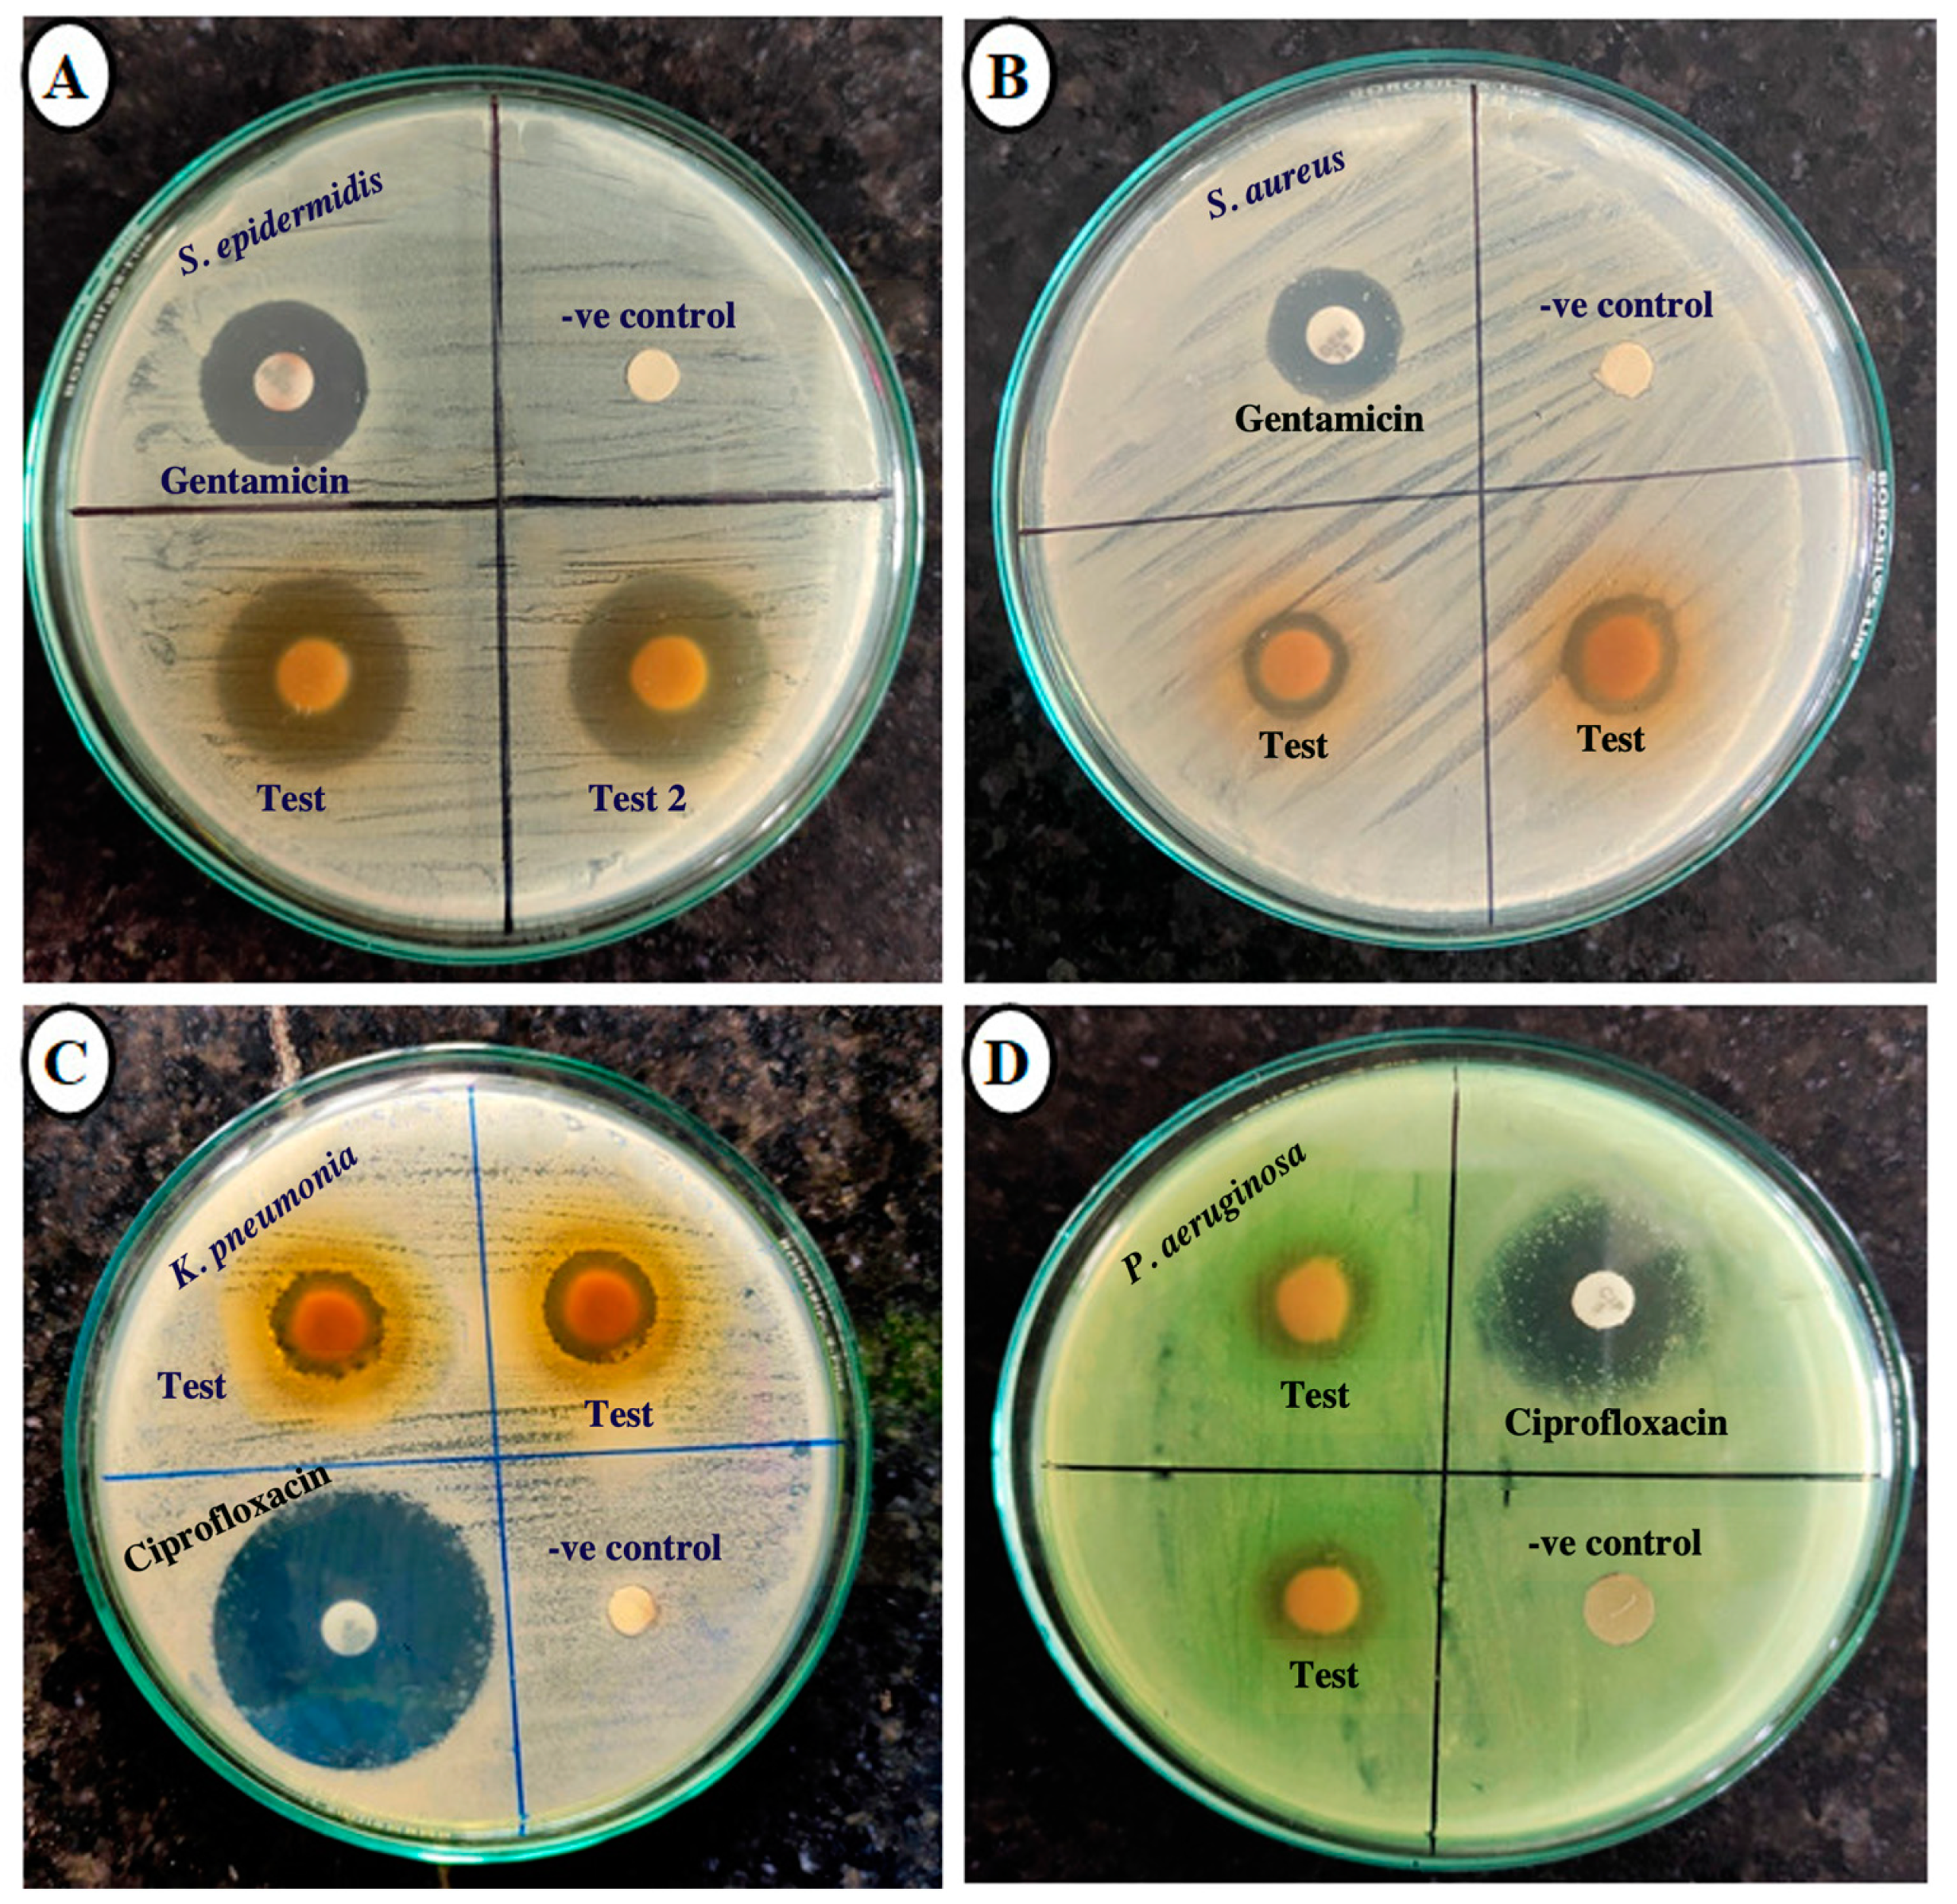
Plants 14 00316 g004

Evaluation of Antioxidant, Xanthine Oxidase-Inhibitory, and Antibacterial Activity of Syzygium cumini Linn. Seed Extracts
Abstract
1. Introduction
2. Results
2.1. Extractive Yield Value
2.2. Quantitative Measurement of Total Flavonoid and Total Phenolic Content
2.3. Quantitative Measurement of Total Carbohydrate Content
2.4. Quantitative Measurement of Antioxidant Activity by Utilizing the DPPH Free Radical Inhibition Method
2.5. Evaluation of Xanthine Oxidase Inhibitory Effect of S. cumini Seed Kernel Extracts
2.6. Screening of Antibacterial Potency of S. cumini Seed Kernel Extracts
3. Discussion
3.1. Extractive Yield Value
3.2. Quantitative Measurement of Total Flavonoid and Total Phenolic Content
3.3. Quantitative Measurement of Total Carbohydrate Content
3.4. Quantitative Measurement of Antioxidant Activity by Utilizing the DPPH Free Radical Inhibition Method
3.5. Evaluation of Xanthine Oxidase-Inhibitory Effect of S. cumini Seed Kernel Extracts
3.6. Antibacterial Potency of S. cumini Seed Kernel Extracts
4. Materials and Methods
4.1. Chemicals Reagents, Solvents, and Standard Drugs
4.2. Plant Sample Authentication
4.3. Extraction of S. cumini Seed Kernel
4.4. Calculation of Extraction Yield
4.5. Measurement of Total Flavonoid Content
4.6. Measurement of Total Phenolic Content
4.7. Measurement of Total Carbohydrate Content
4.8. Evaluation of Antioxidant Activity by Using DPPH Free Radical Inhibition Method
4.9. Xanthine Oxidase-Inhibitory Activity
4.9.1. Preparation of Xanthine, Xantine Oxidase (XO), and Sample Solution
4.9.2. Measurement of Xanthine Oxidase Inhibition
4.10. Antibacterial Activity Screening of S. cumini Seed Kernel Extracts
4.10.1. Bacterial Strains
4.10.2. Preparation of Plant Extracts and Filter Paper Discs
4.10.3. Muller Hinton Agar (MHA) Media Preparation and Sub-Culturing of Bacterial Strains
4.10.4. Preparation of Bacterial Suspension/Inoculums
4.10.5. Exploration and Calculation of Zone of Inhibition (ZOI) Against Bacterial Strains
4.10.6. Calculation of MIC and MBC
4.11. Statistical Analysis
5. Limitations of the Study
6. Conclusions
Supplementary Materials
Author Contributions
Funding
Data Availability Statement
Acknowledgments
Conflicts of Interest
References
- Atanasov, A.G.; Waltenberger, B.; Pferschy-Wenzig, E.-M.; Linder, T.; Wawrosch, C.; Uhrin, P.; Temml, V.; Wang, L.; Schwaiger, S.; Heiss, E.H. Discovery and Resupply of Pharmacologically Active Plant-Derived Natural Products: A Review. Biotechnol. Adv. 2015, 33, 1582–1614. [Google Scholar] [CrossRef] [PubMed]
- Srivastav, V.K.; Egbuna, C.; Tiwari, M. Plant Secondary Metabolites as Lead Compounds for the Production of Potent Drugs. In Phytochemicals as Lead Compounds for New Drug Discovery; Elsevier: Amsterdam, The Netherlands, 2020; pp. 3–14. [Google Scholar]
- Chaudhary, D.; Lamichhane, G. Overview of Natural Products in Nutraceutical Industries. In Herbs, Spices and Their Roles in Nutraceuticals and Functional Foods; Amalraj, A., Kuttappan, S., Varma, A.C.K., Matharu, A., Eds.; Academic Press: New York, NY, USA, 2023; pp. 1–13. ISBN 978-0-323-90794-1. [Google Scholar]
- Aslam, M.S.; Ahmad, M.S. Worldwide importance of medicinal plants: Current and historical perspectives. Recent. Adv. Biol. Med. 2016, 2, 909. [Google Scholar] [CrossRef]
- Zhang, H.; Tsao, R. Dietary Polyphenols, Oxidative Stress and Antioxidant and Anti-Inflammatory Effects. Curr. Opin. Food Sci. 2016, 8, 33–42. [Google Scholar] [CrossRef]
- Adhikari, M.; Thapa, R.; Kunwar, R.M.; Devkota, H.P.; Poudel, P. Ethnomedicinal Uses of Plant Resources in the Machhapuchchhre Rural Municipality of Kaski District, Nepal. Medicines 2019, 6, 69. [Google Scholar] [CrossRef] [PubMed]
- Akhtar, M.S.; Hossain, M.A.; Said, S.A. Isolation and Characterization of Antimicrobial Compound from the Stem-Bark of the Traditionally Used Medicinal Plant Adenium Obesum. J. Tradit. Complement. Med. 2017, 7, 296–300. [Google Scholar] [CrossRef]
- Chopra, A. Ayurvedic Medicine and Arthritis. Rheum. Dis. Clin. North Am. 2000, 26, 133–144. [Google Scholar] [CrossRef]
- Jaiswal, Y.S.; Williams, L.L. A Glimpse of Ayurveda–The Forgotten History and Principles of Indian Traditional Medicine. J. Tradit. Complement. Med. 2017, 7, 50–53. [Google Scholar] [CrossRef]
- Laxminarayan, R.; Duse, A.; Wattal, C.; Zaidi, A.K.; Wertheim, H.F.; Sumpradit, N.; Vlieghe, E.; Hara, G.L.; Gould, I.M.; Goossens, H. Antibiotic Resistance—The Need for Global Solutions. Lancet Infect. Dis. 2013, 13, 1057–1098. [Google Scholar] [CrossRef] [PubMed]
- Sankeshwari, R.M.; Ankola, A.V.; Bhat, K.; Hullatti, K. Soxhlet versus cold maceration: Which method gives better antimicrobial activity to licorice extract against: Streptococcus mutans:? J. Sci. Soc. 2018, 45, 67–71. [Google Scholar] [CrossRef]
- Bagale, R.; Acharya, S.; Gupta, A.; Chaudhary, P.; Chaudhary, G.P.; Pandey, J. Antibacterial and Antioxidant Activities of Prinsepia Utilis Royle Leaf and Seed Extracts. J. Trop. Med. 2022, 2022, 3898939. [Google Scholar] [CrossRef]
- Qamar, M.; Akhtar, S.; Ismail, T.; Wahid, M.; Abbas, M.W.; Mubarak, M.S.; Yuan, Y.; Barnard, R.T.; Ziora, Z.M.; Esatbeyoglu, T. Phytochemical Profile, Biological Properties, and Food Applications of the Medicinal Plant Syzygium cumini. Foods 2022, 11, 378. [Google Scholar] [CrossRef] [PubMed]
- Baliga, M.S.; Bhat, H.P.; Baliga, B.R.V.; Wilson, R.; Palatty, P.L. Phytochemistry, Traditional Uses and Pharmacology of Eugenia Jambolana Lam. (Black Plum): A Review. Food Res. Int. 2011, 44, 1776–1789. [Google Scholar] [CrossRef]
- Ayyanar, M.; Subash-Babu, P. Syzygium cumini (L.) Skeels: A Review of Its Phytochemical Constituents and Traditional Uses. Asian Pac. J. Trop. Biomed. 2012, 2, 240–246. [Google Scholar] [CrossRef] [PubMed]
- Chagas, V.T.; França, L.M.; Malik, S.; Paes, A.M.d.A. Syzygium cumini (L.) Skeels: A Prominent Source of Bioactive Molecules against Cardiometabolic Diseases. Front. Pharmacol. 2015, 6, 259. [Google Scholar] [CrossRef]
- Shrikant Baslingappa, S.; Nayan Singh, J.T.; Meghatai, M.P.; Parag, M.H. Jamun (Syzygium cumini (L.)): A Review of Its Food and Medicinal Uses. Food Nutr. Sci. 2012, 3, 1100–1117. [Google Scholar]
- Kheaw-on, N.; Chaisuksant, R.; Suntornwat, O. Antioxidant capacity of flesh and seed from Syzygium cumini fruits. Asia Pac. Symp. Assur. Qual. Saf. Agri-Foods 2008, 837, 73–78. [Google Scholar] [CrossRef]
- Tham, M.W.; Liew, K.C. Influence of different extraction temperatures and methanol solvent percentages on the total phenols and total flavonoids from the heartwood and bark of Acacia auriculiformis. Europ. J. Wood Wood Prod. 2014, 72, 67–72. [Google Scholar] [CrossRef]
- Venkatesan, T.; Choi, Y.-W.; Kim, Y.-K. Impact of Different Extraction Solvents on Phenolic Content and Antioxidant Potential of Pinus Densiflora Bark Extract. BioMed Res. Int. 2019, 2019, 4. [Google Scholar] [CrossRef] [PubMed]
- Hayouni, E.A.; Abedrabba, M.; Bouix, M.; Hamdi, M. The effects of solvents and extraction method on the phenolic contents and biological activities in vitro of Tunisian Quercus coccifera L. and Juniperus phoenicea L. fruit extracts. Food Chem. 2007, 105, 1126–1134. [Google Scholar] [CrossRef]
- Kumar, M.; Zhang, B.; Nishad, J.; Verma, A.; Sheri, V.; Dhumal, S.; Radha; Sharma, N.; Chandran, D.; Senapathy, M.; et al. Jamun (Syzygium cumini (L.) Skeels) Seed: A Review on Nutritional Profile, Functional food properties, health-promoting applications, and safety aspects. Processes 2022, 10, 2169. [Google Scholar] [CrossRef]
- Radenkovs, V.; Kviesis, J.; Juhnevica-Radenkova, K.; Valdovska, A.; Püssa, T.; Klavins, M.; Drudze, I. Valorization of wild apple (Malus spp.) by-products as a source of essential fatty acids, tocopherols and phytosterols with antimicrobial activity. Plants 2018, 7, 90. [Google Scholar] [CrossRef] [PubMed]
- Ahmed, S.; Jahan, I.A.; Hossain, M.H.; Ahmed, K.S.; Rahman, M.; Zzaman, W.; Hoque, M.M. Bioactive Compounds, Antioxidant Properties and Phenolic Profile of Pulp and Seed of Syzygium cumini. J. Food Meas. Charact. 2021, 15, 1991–1999. [Google Scholar] [CrossRef]
- Priya, S.H.; Prakasan, N.; Purushothaman, J. Antioxidant Activity, Phenolic-Flavonoid Content and High-Performance Liquid Chromatography Profiling of Three Different Variants of Syzygium cumini Seeds: A Comparative Study. J. Intercult. Ethnopharmacol. 2017, 6, 107. [Google Scholar] [CrossRef] [PubMed]
- Pandey, Y.; Upadhyay, S.; Bhatt, S.S. Phyto-Chemical Constituent of Some Wild Edible Fruits of Sikkim Himalaya. J. Pharmacogn. Phytochem. 2018, 7, 1045–1047. [Google Scholar]
- Saeed, N.; Khan, M.R.; Shabbir, M. Antioxidant Activity, Total Phenolic and Total Flavonoid Contents of Whole Plant Extracts Torilis leptophylla, L. BMC Complement. Altern. Med. 2012, 12, 221. [Google Scholar] [CrossRef] [PubMed]
- Pandey, L.K.; Sharma, K.R. Analysis of Phenolic and Flavonoid Content, α-Amylase Inhibitory and Free Radical Scavenging Activities of Some Medicinal Plants. Sci. World J. 2022, 2022, 4000707. [Google Scholar] [CrossRef]
- Al Bratty, M.; Makeen, H.A.; Alhazmi, H.A.; Syame, S.M.; Abdalla, A.N.; Homeida, H.E.; Sultana, S.; Ahsan, W.; Khalid, A. Phytochemical, Cytotoxic, and Antimicrobial Evaluation of the Fruits of Miswak Plant, Salvadora persica, L. J. Chem. 2020, 2020, 4521951. [Google Scholar] [CrossRef]
- Sulaiman, S.F.; Yusoff, N.A.M.; Eldeen, I.M.; Seow, E.M.; Sajak, A.A.B.; Ooi, K.L. Correlation between Total Phenolic and Mineral Contents with Antioxidant Activity of Eight Malaysian Bananas (Musa Sp.). J. Food Compos. Anal. 2011, 24, 1–10. [Google Scholar] [CrossRef]
- Yen, G.C.; Duh, P.D.; Tsai, C.L. Relationship between Antioxidant Activity and Maturity of Peanut Hulls. J. Agric. Food Chem. 1993, 41, 67–70. [Google Scholar] [CrossRef]
- Mahindrakar, K.V.; Rathod, V.K. Ultrasonic Assisted Aqueous Extraction of Catechin and Gallic Acid from Syzygium cumini Seed Kernel and Evaluation of Total Phenolic, Flavonoid Contents and Antioxidant Activity. Chem. Eng. Process.-Process Intensif. 2020, 149, 107841. [Google Scholar] [CrossRef]
- Balyan, U.; Sarkar, B. Aqueous Extraction Kinetics of Phenolic Compounds from Jamun (Syzygium cumini L.) Seeds. Int. J. Food Prop. 2017, 20, 372–389. [Google Scholar] [CrossRef]
- Mahindrakar, K.V.; Rathod, V.K. Valorization of waste Syzygium cumini seed kernels by three-phase partitioning extraction and evaluation of in vitro antioxidant and hypoglycemic potential. Prep. Biochem. Biotechnol. 2021, 51, 1036–1045. [Google Scholar] [CrossRef] [PubMed]
- Kumar, M.; Hasan, M.; Lorenzo, J.M.; Dhumal, S.; Nishad, J.; Rais, N.; Verma, A.; Changan, S.; Barbhai, M.D.; Chandran, D.; et al. Jamun (Syzygium cumini (L.) Skeels) seed bioactives and its biological activities: A review. Food Biosci. 2022, 50, 102109. [Google Scholar] [CrossRef]
- Albalasmeh, A.A.; Berhe, A.A.; Ghezzehei, T.A. A new method for rapid determination of carbohydrate and total carbon concentrations using UV spectrophotometry. Carbohydr. Polym. 2013, 97, 253–261. [Google Scholar] [CrossRef]
- Tharanathan, R.; Muralikrishna, G.; Salimath, P.; Rao, M.R. Plant Carbohydrates—An Overview. Proc. Plant Sci. 1987, 97, 81–155. [Google Scholar] [CrossRef]
- Li, Z.; He, X.; Liu, F.; Wang, J.; Feng, J. A Review of Polysaccharides from Schisandra Chinensis and Schisandra Sphenanthera: Properties, Functions and Applications. Carbohydr. Polym. 2018, 184, 178–190. [Google Scholar] [CrossRef]
- Ghosh, P.; PRadhaN, R.C.; Mishra, S.; Patel, A.S.; Kar, A. Physicochemical and Nutritional Characterization of Jamun (Syzygium cuminii). Curr. Res. Nutr. Food Sci. J. 2017, 5, 25–35. [Google Scholar] [CrossRef]
- Stalikas, C.D. Extraction, separation, and detection methods for phenolic acids and flavonoids. J. Sep. Sci. 2007, 30, 3268–3295. [Google Scholar] [CrossRef] [PubMed]
- Shahidi, F.; Hossain, A. Importance of insoluble-bound phenolics to the antioxidant potential is dictated by source material. Antioxidants 2023, 12, 203. [Google Scholar] [CrossRef] [PubMed]
- Yu, Y.; Shen, M.; Song, Q.; Xie, J. Biological activities and pharmaceutical applications of polysaccharide from natural resources: A review. Carbohydr. Polym. 2018, 183, 91–101. [Google Scholar] [CrossRef] [PubMed]
- Benherlal, P.S.; Arumughan, C. Chemical Composition and in Vitro Antioxidant Studies on Syzygium cumini Fruit. J. Sci. Food Agric. 2007, 87, 2560–2569. [Google Scholar] [CrossRef] [PubMed]
- Jayasree, T.V.; Ravali, T.; Kumar, N.S.; Rao, T.R.; Pavani, B. To compare and evaluate the antioxidant activity of Syzygium cumini seeds by different extracts (ethanol, ethyl acetate, water). Int. J. Res. Eng. Sci. 2022, 10, 571–580. [Google Scholar]
- Tan, A. Novel 1, 2, 3-triazole compounds: Synthesis, in vitro xanthine oxidase inhibitory activity, and molecular docking studies. J. Mol. Struct. 2020, 1211, 128060. [Google Scholar] [CrossRef]
- Singh, J.V.; Bedi, P.M.; Singh, H.; Sharma, S. Xanthine oxidase inhibitors: Patent landscape and clinical development (2015–2020). Expert Opin. Ther. Pat. 2020, 30, 769–780. [Google Scholar] [CrossRef]
- Liu, L.; Zhang, L.; Ren, L.; Xie, Y. Advances in structures required of polyphenols for xanthine oxidase inhibition. Food Front. 2020, 1, 152–167. [Google Scholar] [CrossRef]
- Liang, G.; Nie, Y.; Chang, Y.; Zeng, S.; Liang, C.; Zheng, X.; Xiao, D.; Zhan, S.; Zheng, Q. Protective effects of Rhizoma smilacis glabrae extracts on potassium oxonate- and monosodium urate-induced hyperuricemia and gout in mice. Phytomedicine 2019, 59, 152772. [Google Scholar] [CrossRef] [PubMed]
- Kou, Y.Y.; Li, Y.F.; Xu, M.; Li, W.Y.; Yang, M.; Li, R.L. Effects of rupeng15 powder (rpp15) on monosodium urate crystal-induced gouty arthritis in rats. Evide. Based Complement. Alternat. Med. 2015, 2015, 527019. [Google Scholar] [CrossRef]
- Vasudeva, N.; Singla, P.; Das, S.; Sharma, S.K. Antigout and antioxidant activity of stem and root of Origanum majorana Linn. Am. J. Drug. Discov. Dev. 2014, 4, 102–112. [Google Scholar] [CrossRef]
- Umamaheswari, M.; AsokKumar, K.; Somasundaram, A.; Sivashanmugam, T.; Subhadradevi, V.; Ravi, T.K. Xanthine oxidase inhibitory activity of some Indian medical plants. J. Ethnopharmacol. 2007, 109, 547–551. [Google Scholar] [CrossRef] [PubMed]
- Irawan, C.; Utami, A.; Styani, E.; Putri, I.D.; Putri, R.K.; Dewanta, A.; Ramadhanti, A. Potential of ethanolic extract from ripe Musa balbisiana Colla fruit using ultrasound-assisted extraction as an antioxidant and anti-Gout. Pharmacogn. J. 2021, 13, 1332–1340. [Google Scholar] [CrossRef]
- Daoudi, N.E.; Bouhrim, M.; Ouassou, H.; Bnouham, M. Medicinal plants as a drug alternative source for the antigout therapy in Morocco. Scientifica 2020, 2020, 8637583. [Google Scholar] [CrossRef] [PubMed]
- Chang, W.S.; Lee, Y.J.; Lu, F.J.; Chiang, H.C. Inhibitory effects of flavonoids on xanthine oxidase. Anticancer. Res. 1993, 13, 2165–2170. [Google Scholar] [PubMed]
- Lou, Y.; Gao, Q.; Fan, M.; Waleed, A.A.; Wang, L.; Li, Y.; Qian, H. Ferulic acid ameliorates hyperuricemia by regulating xanthine oxidase. Int. J. Biol. Macromol. 2023, 253, 126542. [Google Scholar] [CrossRef] [PubMed]
- Wang, X.; Cui, Z.; Luo, Y.; Huang, Y.; Yang, X. In vitro xanthine oxidase inhibitory and in vivo anti-hyperuricemic properties of sodium kaempferol-3′-sulfonate. Food Chem. Toxicol. 2023, 177, 113854. [Google Scholar] [CrossRef] [PubMed]
- Wu, N.; Zu, Y.; Fu, Y.; Kong, Y.; Zhao, J.; Li, X.; Li, J.; Wink, M.; Efferth, T. Antioxidant activities and xanthine oxidase inhibitory effects of extracts and main polyphenolic compounds obtained from Geranium sibiricum L. J. Agric. Food Chem. 2010, 58, 4737–4743. [Google Scholar] [CrossRef] [PubMed]
- Sun, Z.R.; Liu, H.R.; Hu, D.; Fan, M.S.; Wang, M.Y.; An, M.F.; Zhao, Y.L.; Xiang, Z.M.; Sheng, J. Ellagic acid exerts beneficial effects on hyperuricemia by inhibiting xanthine oxidase and NLRP3 inflammasome activation. J. Agric Food Chem. 2021, 69, 12741–12752. [Google Scholar] [CrossRef]
- Zhu, M.; Pan, J.; Hu, X.; Zhang, G. Epicatechin gallate as xanthine oxidase inhibitor: Inhibitory kinetics, binding characteristics, synergistic inhibition, and action mechanism. Foods. 2021, 10, 2191. [Google Scholar] [CrossRef] [PubMed]
- Masuda, T.; Shingai, Y.; Takahashi, C.; Inai, M.; Miura, Y.; Honda, S.; Masuda, A. Identification of a potent xanthine oxidase inhibitor from oxidation of caffeic acid. Free. Radic. Biol. Med. 2014, 69, 300–307. [Google Scholar] [CrossRef] [PubMed]
- Zhao, M.; Zhu, D.; Sun-Waterhouse, D.; Su, G.; Lin, L.; Wang, X.; Dong, Y. In vitro and in vivo studies on adlay-derived seed extracts: Phenolic profiles, antioxidant activities, serum uric acid suppression, and xanthine oxidase inhibitory effects. J. Agric. Food Chem. 2014, 62, 7771–7778. [Google Scholar] [CrossRef]
- Gawlik-Dziki, U.; Dziki, D.; Świeca, M.; Nowak, R. Mechanism of action and interactions between xanthine oxidase inhibitors derived from natural sources of chlorogenic and ferulic acids. Food. Chem. 2017, 225, 138–145. [Google Scholar] [CrossRef]
- Asuncion, J.; Domingo, M.M.; Sienna, R.H.; Villa, Z.M.; Loyola, J.A. Comparative study of xanthine oxidase inhibitory activity of methanolic leaf extracts of Calophyllum lancoi (Bitaog), Diospyro spilosanthera (Bolongeta) and Syzygium cumini (Duhat). Europ. J. Mol. Clinic Med. 2020, 7, 4077–4086. [Google Scholar]
- Zhang, L.L.; Lin, Y.M. Antioxidant tannins from Syzygium cumini fruit. Afr. J. Biotechnol. 2009, 8, 2301–2309. [Google Scholar]
- Li, Z.; Wang, H.; Sun, S.; Shao, Z.; Lv, C.; Dong, X.; Wang, L.; Wang, W. Ellagitannins from pomegranate (Punica granatum L.) flower with xanthine oxidase and α-glucosidase inhibitory activities. J. Funct. Foods. 2024, 116, 106153. [Google Scholar] [CrossRef]
- Aryal, B.; Niraula, P.; Khadayat, K.; Adhikari, B.; Khatri Chhetri, D.; Sapkota, B.K.; Bhattarai, B.R.; Aryal, N.; Parajuli, N. Antidiabetic, Antimicrobial, and Molecular Profiling of Selected Medicinal Plants. Evid.-Based Complement. Altern. Med. 2021, 2021, 5510099. [Google Scholar] [CrossRef]
- Khanal, L.N.; Sharma, K.R.; Pokharel, Y.R.; Kalauni, S.K. Assessment of Phytochemical, Antioxidant and Antimicrobial Activities of Some Medicinal Plants from Kaski District of Nepal. Am. J. Plant Sci. 2020, 11, 1383. [Google Scholar] [CrossRef]
- Essawi, T.; Srour, M. Screening of Some Palestinian Medicinal Plants for Antibacterial Activity. J. Ethnopharmacol. 2000, 70, 343–349. [Google Scholar] [CrossRef] [PubMed]
- Lin, J.; Opoku, A.; Geheeb-Keller, M.; Hutchings, A.; Terblanche, S.; Jäger, A.K.; Van Staden, J. Preliminary Screening of Some Traditional Zulu Medicinal Plants for Anti-Inflammatory and Anti-Microbial Activities. J. Ethnopharmacol. 1999, 68, 267–274. [Google Scholar] [CrossRef]
- Meshram, G.A.; Yadav, S.S.; Shinde, D.; Patil, B.; Singh, D. Antibacterial Study and Effect of Ethanolic Extracts of Syzygium cumini Seeds Powder on Glucoamylase Invitro. J. Pharm. Sci. Res. 2011, 3, 1060. [Google Scholar]
- Yadav, A.K.; Saraswat, S.; Sirohi, P.; Rani, M.; Srivastava, S.; Singh, M.P.; Singh, N.K. Antimicrobial Action of Methanolic Seed Extracts of Syzygium cumini Linn. on Bacillus subtilis. AMB Express 2017, 7, 196. [Google Scholar] [CrossRef]
- Yadav, S.S.; Meshram, G.; Shinde, D.; Patil, R.; Manohar, S.M.; Upadhye, M.V. Antibacterial and Anticancer Activity of Bioactive Fraction of Syzygium cumini L. Seeds. HAYATI J. Biosci. 2011, 18, 118–122. [Google Scholar] [CrossRef]
- Saha, R.K.; Zaman, N.M.; Roy, P. Comparative Evaluation of the Medicinal Activities of Methanolic Extract of Seeds, Fruit Pulps and Fresh Juice of Syzygium cumini in Vitro. J. Coast. Life Med. 2013, 1, 300–308. [Google Scholar]
- Santos, C.A.; Almeida, F.A.; Quecán, B.X.; Pereira, P.A.; Gandra, K.M.; Cunha, L.R.; Pinto, U.M. Bioactive properties of Syzygium cumini (L.) skeels pulp and seed phenolic extracts. Front. Microbiol. 2020, 11, 990. [Google Scholar] [CrossRef] [PubMed]
- Bhattarai, B.; Khanal, L.N.; Kalauni, S.K. Antidiabetic and antibacterial activities of Syzygium cumini seeds. J. Nep. Chem. Soc. 2024, 44, 53–162. [Google Scholar] [CrossRef]
- Parimala, S.M.; Salomi, A.A. GC-MS analysis and antimicrobial assessment of Syzygium cumini (L.) skeels seed ethanol extract. J. Pharm. Res. Intl. 2021, 33, 271–283. [Google Scholar] [CrossRef]
- de Carvalho Bernardo, W.L.; Boriollo, M.F.G.; Tonon, C.C.; da Silva, J.J.; Cruz, F.M.; Martins, A.L.; Höfling, J.F.; Spolidorio, D.M.P. Antimicrobial Effects of Silver Nanoparticles and Extracts of Syzygium cumini Flowers and Seeds: Periodontal, Cariogenic and Opportunistic Pathogens. Arch. Oral Biol. 2021, 125, 105101. [Google Scholar] [CrossRef] [PubMed]
- Kothari, V.; Seshadri, S.; Mehta, P. Fractionation of Antibacterial Extracts of Syzygium cumini (Myrtaceae) Seeds. Res. Biotechnol. 2011, 2, 53–63. [Google Scholar]
- Banerjee, J.; Narendhirakannan, R. Phytochemical Analyses, Antibacterial, in Vitro Antioxidant and Cytotoxic Activities of Ethanolic Extract of Syzygium cumini (L.) Seed Extract. Int. J. Pharm. Sci. Res. 2011, 2, 1799–1806. [Google Scholar]
- Pandey, J.; Bhusal, S.; Nepali, L.; Khatri, M.; Ramdam, R.; Barakoti, H.; Giri, P.M.; Pant, D.; Aryal, P.; Rokaya, R.K.; et al. Anti-Inflammatory activity of Artemisia vulgaris leaves, originating from three different altitudes of Nepal. Sci. World J. 2021, 2021, 6678059. [Google Scholar] [CrossRef] [PubMed]
- Mullane, K.; Williams, M. Enhancing reproducibility: Failures from reproducibility initiatives underline core challenges. Biochem. Pharmacol. 2017, 138, 7–18. [Google Scholar] [CrossRef]
- Nguyen, T.L.; Bhattacharya, D. Antimicrobial activity of quercetin: An approach to its mechanistic principle. Molecules 2022, 27, 2494. [Google Scholar] [CrossRef] [PubMed]
- Song, W.; Xin, J.; Yu, C.; Xia, C.; Pan, Y. Alkyl ferulic acid esters: Evaluating their structure and antibacterial properties. Front. Microbiol. 2023, 14, 1135308. [Google Scholar] [CrossRef] [PubMed]
- Periferakis, A.; Periferakis, K.; Badarau, I.A.; Petran, E.M.; Popa, D.C.; Caruntu, A.; Costache, R.S.; Scheau, C.; Caruntu, C.; Costache, D.O. Kaempferol: Antimicrobial properties, sources, clinical, and traditional applications. Int. J. Mol. Sci. 2022, 23, 15054. [Google Scholar] [CrossRef]
- Kang, J.; Liu, L.; Liu, M.; Wu, X.; Li, J. Antibacterial activity of gallic acid against Shigella flexneri and its effect on biofilm formation by repressing mdoH gene expression. Food Control 2018, 94, 147–154. [Google Scholar] [CrossRef]
- Quave, C.L.; Estevez-Carmona, M.; Compadre, C.M.; Hobby, G.; Hendrickson, H.; Beenken, K.E.; Smeltzer, M.S. Ellagic acid derivatives from Rubus ulmifolius inhibit Staphylococcus aureus biofilm formation and improve response to antibiotics. PLoS ONE 2012, 7, e28737. [Google Scholar] [CrossRef] [PubMed]
- Escandón, R.A.; Del Campo, M.; López-Solis, R.; Obreque-Slier, E.; Toledo, H. Antibacterial effect of kaempferol and (−)-epicatechin on Helicobacter pylori. Eur. Food Res. Technol. 2016, 42, 1495–1502. [Google Scholar] [CrossRef]
- Park, M.Y.; Kang, D.H. Antibacterial activity of caffeic acid combined with UV-a light against Escherichia coli O157: H7, Salmonella enterica serovar Typhimurium, and Listeria monocytogenes. Appl. Environ. Microbiol. 2021, 87, e00631-21. [Google Scholar] [CrossRef] [PubMed]
- Li, J.; Zhao, N.; Xu, R.; Li, G.; Dong, H.; Wang, B.; Li, Z.; Fan, M.; Wei, X. Deciphering the antibacterial activity and mechanism of p-coumaric acid against Alicyclobacillus acidoterrestris and its application in apple juice. Int. J. Food. Microbiol. 2022, 378, 109822. [Google Scholar] [CrossRef] [PubMed]
- Chen, K.; Peng, C.; Chi, F.; Yu, C.; Yang, Q.; Li, Z. Antibacterial and antibiofilm activities of chlorogenic acid against Yersinia enterocolitica. Front. Microbiol. 2022, 13, 885092. [Google Scholar] [CrossRef] [PubMed]
- Palani, T.; Shobha, K.; Thirunavukkarasu, P.; Hari, R. In Vitro and in Silico Antigout Arthritic Activities of Ethanolic and Aqueous Stem Extracts of Cissus Quadrangularis-A TLR2 and TLR4 Receptor Approach. J. Appl. Pharm. Sci. 2018, 8, 015–022. [Google Scholar]
- Owen, P.L.; Johns, T. Xanthine Oxidase Inhibitory Activity of Northeastern North American Plant Remedies Used for Gout. J. Ethnopharmacol. 1999, 64, 149–160. [Google Scholar] [CrossRef] [PubMed]
- Umamaheswari, M.; Asokkumar, K.; Sivashanmugam, A.; Remyaraju, A.; Subhadradevi, V.; Ravi, T. In Vitro Xanthine Oxidase Inhibitory Activity of the Fractions of Erythrina Stricta Roxb. J. Ethnopharmacol. 2009, 124, 646–648. [Google Scholar] [CrossRef]
- Phuyal, N.; Jha, P.K.; Raturi, P.P.; Rajbhandary, S. In Vitro Antibacterial Activities of Methanolic Extracts of Fruits, Seeds, and Bark of Zanthoxylum Armatum DC. J. Trop. Med. 2020, 2020, 2803063. [Google Scholar] [CrossRef] [PubMed]
- Samydurai, P.; Saradha, M. Effects of various solvent on the extraction of antimicrobial, antioxidant phenolics from the stem bark of Decalepis hamiltonii Wight and Arn. Asian J. Res. Pharm Sci. 2016, 6, 129–134. [Google Scholar]
- Neupane, S.; Bajracharya, S.; Thada, S.; Bakabal, A.; Khadka, R.B.; Devkota, H.P.; Pandey, J. Total phenolic and flavonoid contents, and preliminary antioxidant, xanthine oxidase inhibitory and antibacterial activities of fruits of lapsi (Choerospondias axillaris Roxb.), an underutilized wild fruit of Nepal. Appl. Sci. 2023, 13, 8945. [Google Scholar] [CrossRef]

| Extracts | Total Flavonoid Content (μg QE/mg Extract) | Total Phenol Content (μg GAE/mg Extract) | Total Carbohydrate Content (μg GE/mg Extract) |
|---|---|---|---|
| Hexane extract | 21.24 ± 1.73 a | 38.89 ± 1.05 a | 5.57 ± 0.57 a |
| Methanol extract | 127.78 ± 0.89 b | 153.81 ± 2.49 b | 475.61 ± 2.14 b |
| Zone of Inhibition in mm (Mean ± SD) | ||||
|---|---|---|---|---|
| Bacterial Strains | Hexane Extract | Methanol Extract | Ciprofloxacin | Gentamicin |
| S. aureus | 9.56 ± 0.0.81 | 15.33 ± 0.57 | - | 16.63 ± 0.47 |
| S. epidermidis | 10.16 ± 1.04 | 19.00 ± 1.00 | - | 18.66 ± 0.57 |
| B. cereus | 9.33 ± 0.57 | 14.68± 0.51 | - | 16.85 ± 0.31 |
| S. pneumoniae | 10.00 ± 1.00 | 12.00 ± 1.00 | - | 15.00 ± 1.00 |
| E. coli | 9.00 ± 1.00 | 16.00 ± 1.00 | 23.16 ± 0.76 | - |
| K. pneumonia | 14.66 ± 1.10 | 18.33 ± 0.57 | 33.66 ± 1.52 | - |
| P. aeruginosa | 9.36 ± 0.70 | 16.33 ± 0.57 | 23.33 ± 1.52 | - |
| S. enteritidis | 9.53 ± 0.20 | 16.63 ± 0.55 | 22.56 ± 0.60 | - |
| MIC and MBC Values of Samples (mg/mL) | ||||
|---|---|---|---|---|
| Bacterial Strains | Hexane Extract | Methanol Extract | ||
| MIC | MBC | MIC | MBC | |
| S. aureus | 2.68 ± 0.97 | 4.66 ± 2.45 | 0.65 ± 0.22 | 1.04 ± 0.45 |
| S. epidermidis | 2.12 ± 0.97 | 2.69 ± 0.97 | 0.32 ± 0.11 | 0.52 ± 0.22 |
| B. cereus | 4.66 ± 2.45 | 7.5 ± 0.00 | 1.04 ± 0.45 | 1.56 ± 0.00 |
| S. pneumoniae | 2.12 ± 0.97 | 4.66 ± 2.45 | 2.60 ± 0.90 | 3.12 ± 0.00 |
| E. coli | 6.08 ± 2.45 | 10.00 ± 4.33 | 1.04 ± 0.45 | 1.30 ± 0.45 |
| K. pneumonia | 1.30 ± 0.45 | 2.12 ± 0.97 | 0.52 ± 0.22 | 0.78 ± 0.00 |
| P. aeruginosa | 4.66 ± 2.45 | 7.5 ± 0.00 | 2.08 ± 0.90 | 2.60 ± 0.90 |
| S. enteritidis | 4.66 ± 2.45 | 6.08 ± 2.45 | 1.30 ± 0.45 | 2.08 ± 0.90 |
Disclaimer/Publisher’s Note: The statements, opinions and data contained in all publications are solely those of the individual author(s) and contributor(s) and not of MDPI and/or the editor(s). MDPI and/or the editor(s) disclaim responsibility for any injury to people or property resulting from any ideas, methods, instructions or products referred to in the content. |
© 2025 by the authors. Licensee MDPI, Basel, Switzerland. This article is an open access article distributed under the terms and conditions of the Creative Commons Attribution (CC BY) license (https://creativecommons.org/licenses/by/4.0/).
Share and Cite
Pandey, J.; Jaishwal, N.; Jayswal, M.; Gupta, D.C.; Dhakal, B.; Budean, D.; Lamichhane, G.; Devkota, H.P. Evaluation of Antioxidant, Xanthine Oxidase-Inhibitory, and Antibacterial Activity of Syzygium cumini Linn. Seed Extracts. Plants 2025, 14, 316. https://doi.org/10.3390/plants14030316
Pandey J, Jaishwal N, Jayswal M, Gupta DC, Dhakal B, Budean D, Lamichhane G, Devkota HP. Evaluation of Antioxidant, Xanthine Oxidase-Inhibitory, and Antibacterial Activity of Syzygium cumini Linn. Seed Extracts. Plants. 2025; 14(3):316. https://doi.org/10.3390/plants14030316
Chicago/Turabian StylePandey, Jitendra, Nitesh Jaishwal, Mamta Jayswal, Deep Chand Gupta, Bishnu Dhakal, David Budean, Gopal Lamichhane, and Hari Prasad Devkota. 2025. "Evaluation of Antioxidant, Xanthine Oxidase-Inhibitory, and Antibacterial Activity of Syzygium cumini Linn. Seed Extracts" Plants 14, no. 3: 316. https://doi.org/10.3390/plants14030316
APA StylePandey, J., Jaishwal, N., Jayswal, M., Gupta, D. C., Dhakal, B., Budean, D., Lamichhane, G., & Devkota, H. P. (2025). Evaluation of Antioxidant, Xanthine Oxidase-Inhibitory, and Antibacterial Activity of Syzygium cumini Linn. Seed Extracts. Plants, 14(3), 316. https://doi.org/10.3390/plants14030316

